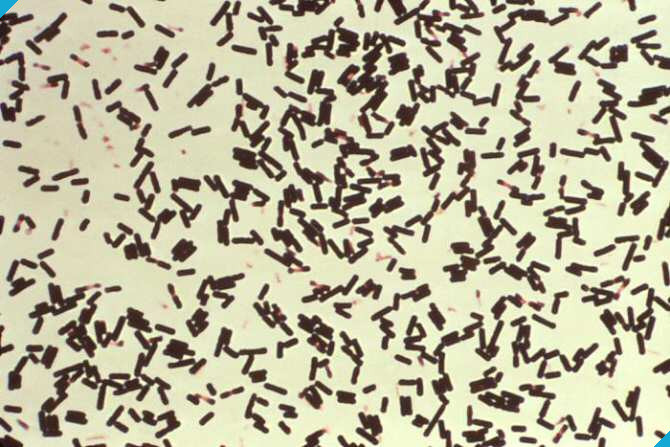

Links
potencialmente
interesantes

Daniel Bernoulli, el cientÃfico que unió la fÃsica, las matemáticas y la medicina
Daniel Bernoulli (1700–1782) fue uno de los científicos más brillantes del siglo XVIII. Su trabajo abarca disciplinas tan diversas como la física, las matemáticas, la hidrodinámica y la medicina. A pesar de vivir a la sombra de su famoso apellid...

ChatGPT está probando una misteriosa nueva función llamada “Study Together” - Codigo Geek
OpenAI está probando en ChatGPT una función aún no anunciada llamada “Study Together”, la cual apareció recientemente en el menú lateral de algunos usuarios.

"Tomaremos caminos separados". Un conflicto interno motiva al creador de Linux a suprimir de un plumazo 10 años de trabajo
Todo proyecto de desarrollo de software está condicionado, en menor o mayor medidas, por tensiones internas. Incluso proyectos tan consolidados como el del...

Cinco móviles de oferta en el Prime Day por menos de 500 euros: Samsung, Xiaomi, Nothing y más
Tanto el Black Friday como el Prime Day son dos campañas perfectas para comprar un móvil, ya que normalmente solemos encontrar ofertas que no vemos durante el...

Entre 2026 y 2028 España se va a convertir en un paraíso de los eclipses. Y tenemos nuevos mapas para saber dónde se verán mejor
Los años 2026 y 2027 destacarán en lo astronómico: dos eclipses totales en dos años consecutivos que podrán ser vistos desde distintas zonas de España. Y si...
Convertir toxinas en aliados: nueva estrategia biotecnológica para cruzar barreras celulares
Unos científicos han descubierto un modo de idear nuevas técnicas con las que administrar fármacos proteicos en la piel o a través de la piel. Concretamente, se trata de técnicas basadas en proteínas recombinantes capaces de modular la permeabili...

He probado la Glyph Matrix del Nothing Phone (3). Y ahora la quiero en todos los teléfonos del mercado
Llevo utilizando del Nothing Phone (3) desde hace aproximadamente dos semanas. Es el Nothing más caro en la historia de la compañía, pero también el mejor que...

Nothing Phone (3), análisis: estaba aburridísimo de los móviles de siempre. Hasta que llegó el primer Nothing de gama alta
"Make tech fun again". Más allá de similitudes con eslóganes de ciertos personajes públicos, el mensaje de Nothing no es solo marketing: es la filosofía que...

El extraño caso de una supernova con dos explosiones en vez de una
Por primera vez, se ha obtenido evidencia visual de que una estrella ha muerto con una doble explosión. Al estudiar los restos centenarios de la supernova SNR 0509-67.5 con el conjunto de telescopios VLT (Very Large Telescope), del Observatorio E...

La población del Antiguo Egipto según el análisis de un genoma
Por vez primera, unos científicos han conseguido secuenciar con éxito el genoma entero de alguien del Antiguo Egipto. Concretamente, se trata de un hombre que vivió en algún periodo situado entre hace 4.500 años y hace 4.800, la época en que come...

La OTAN ha planteado un escenario: si China ataca a Taiwán, Rusia y Corea del Norte también lo harán... pero a Europa
Una entrevista del New York Times ha abierto la posibilidad de un escenario que atañe a una gran cantidad de naciones. El secretario general de la OTAN, Mark...

"Es como tu mejor amigo": la nueva y distópica moda de usar una IA como guía en viajes psicodélicos para tratar adicciones
Imagina un terapeuta disponible las 24 horas del día, los siete días de la semana, que conoce tus pensamientos más profundos y te guía en una de las...